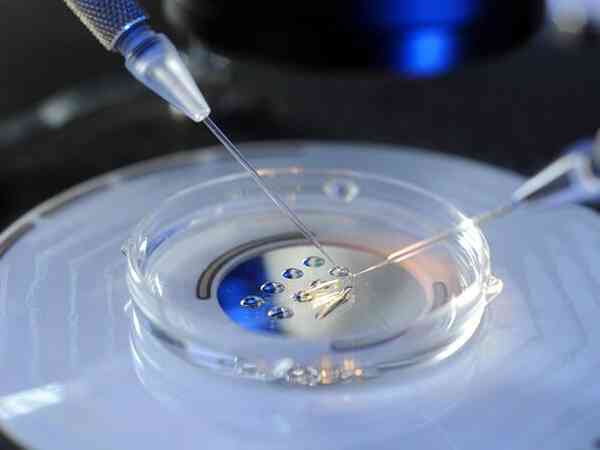

摘要
泰國洗精術的價格大概在8000-10000元左右,若是加上做試管的費用,大概一共在11-12萬元左右。不過由於每個人的身體情況、用藥程度、治療方案等不同,因此其具體費用也是不固定的。泰國的輔助生殖技術,目前在全世界也都是非常出名的,其先進的技術和裝置設施也是受到了國內外眾多患者的青睞,而對於HIV患者想通過試管技術懷寶寶的,那麼洗精術就是目前最好的選擇,洗精術主要是篩選出健康的精子,並且用精子來進行試管技術,而三代試管技術也就是PGD,主要是篩查胚胎有沒有問題,所以洗精術加三代試管是能夠更好的確保健康性,並且價格方面,本文也整理了一些相關資訊,這裡可做參考。

HIV洗精+三代試管要花60萬泰銖
對於HIV患者來講,要想懷上健康的孩子,那麼就需必須要通過洗精後,才能進行試管嬰兒,在泰國普遍的一個洗精價格是在5-15萬泰銖左右,而三代試管技術也是泰國常用的輔助生殖技術,價格方面普遍是在45-60萬泰銖左右,具體的情況如下:
從以上的內容中我們可以知道,患有hiv的男性在泰國做試管之前需要先進行洗精,費用大概是在1-3萬元左右,不過如果加上後續做三代試管的費用,那麼總的收費是在1-15萬元,以下整理了HIV洗精的具體收費:

洗精術需要採血採精
1.對於高病毒載量和低C4含量的患者,體外清洗艾滋病毒精子的費用大概是3萬元;
2.對於低病毒載量和高C4含量的患者,體外清洗艾滋病毒精子的費用大概是1萬元。
運用泰國三代試管洗精術,不僅能降低男性精子畸形率,提高精子活力保證精子質量,還能實現優生優育。因此艾滋病患者通過洗精術篩選健康精子,再加上三代試管嬰兒,是可以大大的提高懷上健康的孩子機率。
近年來,國內越來越多的不孕不育家庭赴泰國做試管嬰兒,主要原因是泰國試管嬰兒技術受眾廣泛,能滿足客戶各種各樣的試管需求,比如說HIV陽性洗精、雙胞胎、A卵B懷、高齡求子等,若有計劃前往泰國做試管,可通過本列表查詢泰國試管嬰兒相關需求。
| PGD | HIV陽性洗精 | HIV洗精費用 | 供卵 | 雙胞胎 |
| 凍卵 | 單身 | 同性 | A卵B懷 | 高齡 |
| 生男孩 | 第三代 | 供精 | 生男生女 |